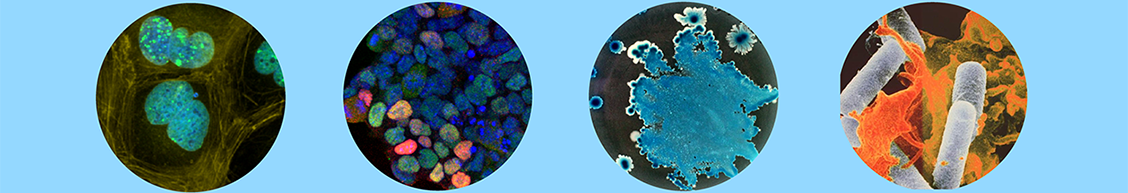

What is the Copenhagen Bioscience PhD Programme?
The Copenhagen Bioscience PhD programme is an initiative from the Novo Nordisk Foundation that began in 2016, offering up to 16 motivated international students per year funding to join a four-year rotation PhD programme at the Copenhagen Bioscience Cluster in Greater Copenhagen. The Copenhagen Bioscience PhD Programme is divided into a pre-doc year followed by three years of PhD training.
What is a rotation project and when do I choose a lab?
Rotation projects are short lab projects. At the beginning of the pre-doc (first) year, students complete three two-week rotation projects in labs of their choice within the Copenhagen Bioscience Cluster. Students can approach any potential supervisor listed that year about doing a rotation project. The rotation projects are primarily intended to give students and potential supervisors an extended opportunity to get to know each other; and for students to think deeply about and discuss the research going on in the labs they are interested in joining. After completing the rotation projects, students should make an agreement with one of their rotation project supervisors, and join that group for their long-term project (expected to become the PhD project).
What happens in the pre-doc year?
In the pre-doc year, students complete a 8-day lecture course, followed by three short rotation projects. After finishing the rotation projects, students join one of the groups they rotated with, start work on their long-term lab project, and attend regular literature discussion sessions in parallel. At the end of the pre-doc year, students must pass a qualifying exam in order to be enrolled as PhD students at DTU or UCPH for years 2-4.
What is the Copenhagen Bioscience Cluster?
The Copenhagen Bioscience Cluster includes the four Novo Nordisk Foundation (NNF) Research Centers in Greater Copenhagen: Center for Protein Research, Center for Stem Cell Medicine, Center for Basic Metabolic Research, and Center for Biosustainability. All the supervisors involved with the Copenhagen Bioscience PhD Programme are based at an NNF Research Center. Students joining the Copenhagen Bioscience PhD Programme join one of the four NNF Research Centers – although the Copenhagen Bioscience PhD Programme and its curriculum spans all four Centers.
How do I join?
For enrolment in September of a given year, candidates must apply in the Autumn of the previous year. Prospective students must apply to the Novo Nordisk Foundation for funding by completing the application form on their website and providing all requested documents. Candidates select one of the Research Centers in the application. If an applicant is successful, they then join the Research Center they applied to, at the University where that Research Center is based (either the University of Copenhagen (CPR, reNEW, CBMR) or the Technical University of Denmark (CFB)). Students do not decide upon their supervisor until after they have completed the rotation projects, but applicants can indicate the research topics and/or supervisors that interest them in the application form.
Am I eligible?
Applicants must have completed an education that brings them to the entry level for a PhD. It is required that applicants hold at least one degree from outside Denmark, and/or have been living and working outside Denmark for a significant period of time. Applicants must provide documentation of their English language ability. The programme funding is open to all nationalities, provided all eligibility requirements are fulfilled. For full details of the eligibility requirements, please visit the application webpage.